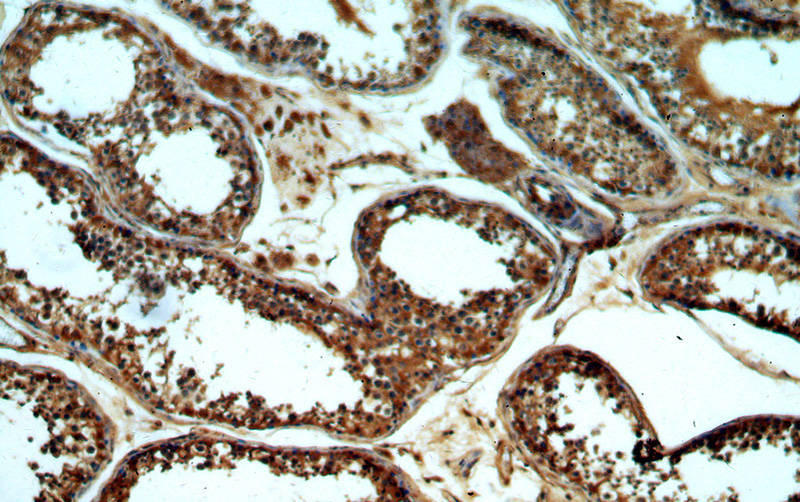
Immunohistochemical of paraffin-embedded human testis using Catalog No:111011(GNRHR antibody) at dilution of 1:50 (under 10x lens)

-
Product Name
GNRHR antibody
- Documents
-
Description
GNRHR Rabbit Polyclonal antibody. Positive IP detected in MCF-7 cells. Positive WB detected in MCF7 cells, mouse ovary tissue, mouse testis tissue, PC-3 cells. Positive IHC detected in human testis tissue, human ovary tissue, mouse testis tissue. Positive FC detected in MCF-7 cells. Observed molecular weight by Western-blot: 38 kDa
-
Tested applications
ELISA, WB, IHC, FC, IP
-
Species reactivity
Human, Mouse; other species not tested.
-
Alternative names
GnRH R antibody; GnRH receptor antibody; GNRHR antibody; GNRHR1 antibody; GRHR antibody; LHRHR antibody; LRHR antibody
-
Isotype
Rabbit IgG
-
Preparation
This antibody was obtained by immunization of Peptide (Accession Number: NM_000406). Purification method: Antigen affinity purified.
-
Clonality
Polyclonal
-
Formulation
PBS with 0.02% sodium azide and 50% glycerol pH 7.3.
-
Storage instructions
Store at -20℃. DO NOT ALIQUOT
-
Applications
Recommended Dilution:
WB: 1:200-1:2000
IP: 1:200-1:2000
IHC: 1:20-1:200
-
Validations

MCF7 cells were subjected to SDS PAGE followed by western blot with Catalog No:111011(GNRHR antibody) at dilution of 1:500

1X10^6 MCF-7 cells were stained with 0.2ug GNRHR antibody (Catalog No:111011, red) and control antibody (blue). Fixed with 90% MeOH blocked with 3% BSA (30 min). Alexa Fluor 488-congugated AffiniPure Goat Anti-Rabbit IgG(H+L) with dilution 1:1000.
Immunohistochemical of paraffin-embedded human testis using Catalog No:111011(GNRHR antibody) at dilution of 1:50 (under 10x lens)

Immunohistochemical of paraffin-embedded human testis using Catalog No:111011(GNRHR antibody) at dilution of 1:50 (under 40x lens)

IP Result of anti-GNRHR (IP:Catalog No:111011, 4ug; Detection:Catalog No:111011 1:500) with MCF-7 cells lysate 1040ug.
-
Background
GNRHR, also named as GRHR, belongs to the G-protein coupled receptor 1 family. GNRHR is a receptor for gonadotropin releasing hormone (GnRH) that mediates the action of GnRH to stimulate the secretion of the gonadotropic hormones luteinizing hormone (LH) and follicle-stimulating hormone (FSH). It mediates its action by association with G-proteins that activate a phosphatidylinositol-calcium second messenger system. Isoform2 of GNRHR may act as an inhibitor of GnRH-R signaling. Defects in GNRHR are a cause of idiopathic hypogonadotropic hypogonadism (IHH). Defects in GNRHR are a cause of fertile eunuch syndrome. The antibody only recognizes the isoform1 of GNRHR. The predicted unmodified molecular weight of the human GNRHR is ~38 kDa, the larger band (50-60 kDa) is likely to represent a glycosylated form of GNRHR.
-
References
- Torrealday S, Lalioti MD, Guzeloglu-Kayisli O, Seli E. Characterization of the gonadotropin releasing hormone receptor (GnRHR) expression and activity in the female mouse ovary. Endocrinology. 154(10):3877-87. 2013.
- Karampelas T, Argyros O, Sayyad N. GnRH-Gemcitabine conjugates for the treatment of androgen-independent prostate cancer: pharmacokinetic enhancements combined with targeted drug delivery. Bioconjugate chemistry. 25(4):813-23. 2014.
Related Products / Services
Please note: All products are "FOR RESEARCH USE ONLY AND ARE NOT INTENDED FOR DIAGNOSTIC OR THERAPEUTIC USE"
